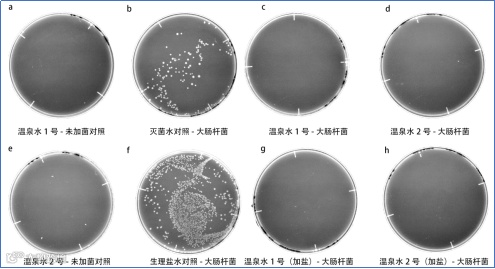
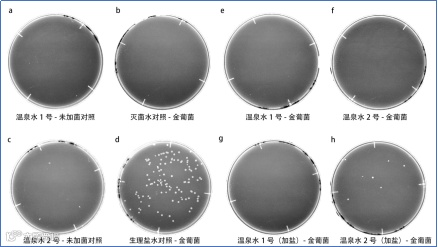

自疫情发生两年多来,各方都在积极研究和探索新冠肺炎的防御、治疗和康复方法。有专家提出,泡温泉或洗热水澡可以杀灭新冠病毒,众多名人也为此站台支持。事实果真如此吗?
目前还缺乏系统研究证明温泉能够对冠状病毒产生直接影响,但多项研究表明,温泉疗法能够提升免疫力。也就是说,通过“温泉+”的康疗方式可以增强人体免疫系统,从而有效抵御病毒入侵,降低感染风险。“温泉+”以温泉疗法为主导,叠加森林疗法、气候疗法、运动疗法、盐疗、食疗、传统医学等要素,构建一套健康增进体系,综合对免疫系统产生积极作用。
一
温泉疗法提升免疫力的科学机制
温泉疗法提升免疫力的科学机制主要是通过温泉沐浴产生的温热刺激、所含矿物成分的效果与温泉所在地的自然气候等健康手段对人体产生的综合性刺激,引发体内自律神经系统、免疫系统等产生积极反应,从而激活能够使人体各项机能趋于正常化的自然治愈力。

免疫力与体温、血液循环、新陈代谢、消化吸收、排汗排毒、心理状态、睡眠等机能息息相关,而温泉几乎在这些方面都有独特的调理功效。主要从以下三个方面发生作用:
温热作用
温泉疗法直接参与体温调节,维系体温平衡,增强身体机能;促进血管扩张,增加局部血流;改善细胞代谢;减轻疼痛,降低肌肉张力,增加白血球等免疫细胞。
日本著名健康养生专家石原结实博士著有《体温决定生老病死》系列书籍,阐述了体温与免疫力的关系:人体理想的温度是36.5-36.8℃。正常范围内,体温升高1℃,免疫力将增强5-6倍。
石原结实博士认为,温热效应提升免疫力的机制主要是因为:
温热效果,促进血液循环;
温水(38-41℃)刺激副交感神经,起到放松身体的作用。热水(42℃以上)刺激交感神经,使身心活性化;
温热效果使白血球活性化,提升免疫力;
提高血栓溶解性,净化血液。

人体温度与健康的关系 图 |《体温决定生老病死》
皮肤净化
作为一种溶剂,温泉可溶解皮肤上的老化物质,加上水流的冲刷作用,能使皮肤血流增加,促进皮肤代谢,维持皮肤洁净,降低感染传染病的风险。
西南大学药学院陆军教授团队曾就温泉水的体外抑菌作用开展了一次实验。实验采用了两种温泉水——统景的硫酸钙镁泉和宁波的重碳酸钠泉。结果证明,两种温泉水均可以抑制革兰氏阳性菌与阴性菌的生长。

生化作用
温泉富含几十种有益人体的矿物质,许多元素对提升人体免疫力有极好的功效。例如,钙能刺激心血管,影响神经细胞和内分泌腺兴奋性,提高对传染病的抵抗能力;硒对抗体内过氧化作用和重金属中毒参与噬菌防御作用。

温泉疗法提升免疫力的方式以浴疗最为普遍,包括浸浴、淋浴、水中运动、机械水浴等;此外还有饮疗、吸入、含漱等疗法。
二
全球“温泉与免疫力”研究荟萃
全球多个国家就温泉疗法对人体免疫力的作用机制开展了进一步研究,证实温泉疗法对人体免疫系统有积极影响,正确有效地开展温泉疗法或可降低感染新冠病毒的风险。
日本
温泉通过两种方式增强免疫系统
日本九州大学(Kyushu University)别府医院副教授前田丰木博士(Toyoki Maeda)通过研究表明,温泉水主要以两种重要的方式增强人体免疫系统。
缓解压力
在温泉中放松有助于减轻经常伤害身体的压力。泡温泉就是一种降低压力荷尔蒙的行为,可以使身体更容易对抗抗原。根据 Bath & Spa 医学研究员早坂信哉(Shinya Hayasaka)的说法,许多温泉都处于优美静谧的自然环境中,环境因素放大了这种放松效果。
根据日本卫生学会森林医学研究会会长李卿教授的研究,温泉疗法+森林疗法可以逐渐降低人体的尿中肾上腺激素浓度(与精神压力有关)、甲肾上腺激素(与身体压力有关)以及皮质醇浓度(与精神和身体压力均有关),从而起到减压的作用。在接受森林浴后,NK细胞(自然杀伤细胞,免疫细胞的一种)活性显著增加,且四种抗癌蛋白质也都有所增加,证明免疫系统得到增强。

体温和免疫系统
温泉比普通的沐浴对身体更有益,因为温泉富含多种矿物质和微量元素,能够促进健康的血液循环,帮助身体排出那些增加压力的物质。此外,泡温泉加热身体会激活与免疫系统相关的细胞。根据温泉疗法医生大村康一郎(Koichiro Omura)的说法,在41℃的温泉中浸泡15-30分钟会增加抵抗病毒的NK细胞(自然杀伤细胞)的活性。因此,温泉有可能在抵御新冠病毒以及其他疾病方面发挥作用。但是,温泉对已经感染病毒的细胞没有作用。
前田博士认为病毒不太可能在温泉中传播。因为新冠病毒和其他病毒很难在如此炎热潮湿的环境中生存,浸泡在温热的水中,感染冠状病毒的风险极低。相比温泉水,游客更需注意的是温泉场所的通风情况、消毒情况以及自我防护。室内温泉设施必须确保适当的通风。客人必须遵守防疫安全距离,佩戴口罩并随时为双手消毒,避免扎堆聚集。

日本玉造温泉长乐园 图 | www.nippon.com
意大利
温泉疗法通过对细胞介导和体液的改变增强免疫系统
意大利帕多瓦大学(University of Padova)物理及康复医学院教授、亚太温泉研究院特聘顾问斯德范鲁·马斯诺(Stefano Masiero)一项研究表明,温泉疗法可通过减轻精神压力和直接干预,改变细胞介导和体液的变化来调节异常炎症和增强免疫系统。人体免疫力的变化主要和参与免疫反应的细胞(如中性粒细胞和单核细胞)的水平、细胞活性的增加以及由失调炎症产生的促炎细胞因子的减少有关。临床前模型已经在细胞水平上证明了温泉疗法具有抗炎和免疫抑制作用,临床试验也证实了这一点。在小鼠特应性皮炎模型中,高浓度温泉水治疗后血清中促炎细胞因子IL-1β、IL-13、TNF-α水平显著降低。同样,在接受温泉疗法和泥疗法的患者中,炎症细胞因子的活性是通过抗炎IGF-1的增加以及促炎细胞因子TNF-α和IL-1β水平的降低来调节的。
温泉疗法对人体免疫力的影响不仅与抗炎和免疫抑制作用有关,而且似乎还源于细胞介导免疫的改善。氡温泉浴可以通过小幅但持久地增加单核细胞水平来增强细胞介导的免疫力,而硫磺温泉浴已被证明可以提高中性粒细胞的短期存活能力。

西班牙
抗炎作用或为温泉疗法临床受益的基础
西班牙埃斯特雷马杜拉大学(University of Extremadura)理学院生理学系免疫生理学研究小组一项研究指出,过去二十年许多研究已经解释了有效的免疫学机制,根据研究机制,抗炎作用可能是温泉疗法临床受益的基础。
在几种与炎症相关的低度病变(尤其是风湿性疾病)中,温泉疗法和泥疗法可降低促炎细胞因子TNF-α、IL-1β和调节细胞因子IL-6的血清浓度,并增强抗炎生长因子IGF-1。
温泉疗法的有益效果也包含细胞免疫反应,尽管关于这方面的免疫反应研究并不多。课题组发现参与试验的骨关节炎患者表现出循环中性粒细胞功能(即吞噬和杀微生物活性)下降,在接受温泉泥浆治疗后得到显著改善。
美国
温泉疗法改善免疫,激活单核细胞并使其准备好应对感染
美国魏玛研究所(Weimar Institute)一项研究认为,温泉疗法是一种加热身体和改善免疫的方法。在第一项小型实验中,参与者浸泡在39.4℃的热水中模拟发烧,测试温泉浴对单核细胞和TNF-α的影响。体表测试表明在浴疗后有助于感染的受体 CD14和CD11b增加。体内测试在浴疗后3小时进行,单核细胞对内毒素的反应得到改善,这是由更多的TNF-α释放所证明的。实验结论认为,温泉疗法可以激活单核细胞并使其准备好应对感染。
另一项实验旨在测试温泉疗法与冷泉疗法对免疫系统的综合影响。结论认为,冷热交替疗法显著增加了白细胞、粒细胞、淋巴细胞和单核细胞的数量。温泉疗法后的短暂冷疗可有效增加白细胞数、NK细胞活性和IL-6水平。
芬兰
桑拿浴冷热交替疗法增强免疫系统
2020年,芬兰桑拿浴被列入联合国教科文组织非物质文化遗产名录。桑拿浴最大的亮点是冷热交替疗法。东芬兰大学(University of Eastern Finland)一项研究证实桑拿浴的冷热交替疗法对免疫系统有益。该研究的首席研究员加里·劳卡宁(Jari Laukkanen)探索了桑拿浴引起的血压和血液循环变化等生理机制,发现桑拿浴在呼吸系统上可以增加肺部的抵抗力,桑拿浴长期使用者发生感冒几率是没有使用者的一半。
发表在《欧洲流行病学杂志》(European Journal of Epidemiology)上的一项研究成果显示,与很少或从不开展桑拿浴的人相比,经常做桑拿的人患上肺炎的风险降低27%。此外,经常做桑拿还降低了哮喘和其他胸科疾病的风险。

芬兰公共桑拿房 图 | Kuvio.com
中国
温泉疗法在中医层面对免疫力的影响
三益中医健康管理首席专家、原浙江农林大学教授俞益武认为心畅、气达、血清与人体免疫功能的调理息息相关。
心畅主要指情绪与精神,这是人体发挥正常机能的关键因素,也是广义免疫的核心因素。中医常说的“心主神明”,这个心主要指精神和情绪。而温泉的第一作用就是放松情绪,缓解焦虑。温泉可以为顾客提供各类安抚:触觉安抚、环境安抚、汤水安抚、温热安抚、音乐安抚……
气达即呼吸畅顺,肺的血氧交换能力正常,血氧饱和度正常。只有胸腹式呼吸才能保证血氧充分交换。温泉自动使人进入胸腹式呼吸。温泉的直接治疗作用使痰粘度下降,对呼吸道起净化作用,使呼吸道粘膜正常化,从而改善呼吸道防御机能;并间接改善肾上腺皮质、髓质的机能,促进循环机能,强化固有免疫(非特异性免疫)。
血清:正常血液循环是血氧、营养物质输送和代谢废物排出的保障。血液、组织和细胞间液污染,是发生细胞因子风暴的关键因素,也是免疫因子传递、荷尔蒙分子传递等的一切保障。血清是特异性、非特异性免疫正常发挥的保障。温泉中的有益矿物成分通过透皮吸收,可以协助清除组织间液的代谢废物,加速细胞间物质转移和细胞膜活性,间接净化血液。
结 语
SUNSHINE HOME
↓↓↓点击视频号查看阳光人家粤语宣传片
↓↓↓点击以下地图,一键导航阳光人家
|
|||
|
|||
|
|||
|
THE QR CODE
长按二维码
成为阳光家人
▼
点击“阅读原文”预约参观

